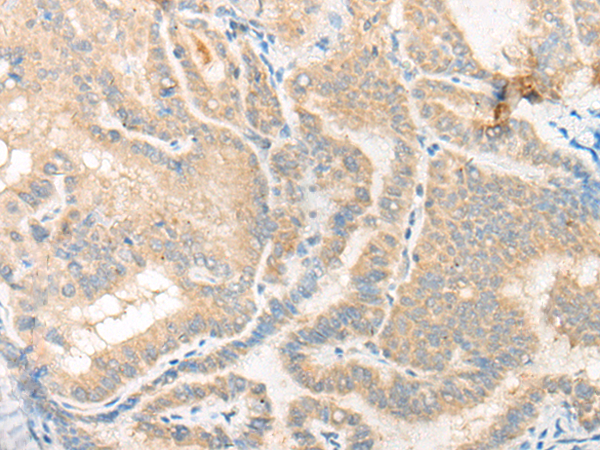

儲(chǔ) 存: 冷凍(-20℃)
宿 主: Rabbit
反應(yīng)種屬: Human, Rat
標(biāo) 記 物: Unconjugate
Background:
Serine/threonine-protein kinase involved in transcription regulation, apoptosis and steroidogenic gene expression. Phosphorylates JUN and RUNX2. Seems to negatively regulate apoptosis by promoting FADD phosphorylation. Enhances androgen receptor-mediated transcription. May act as a transcriptional corepressor for NK homeodomain transcription factors. The phosphorylation of NR5A1 activates SF1 leading to increased steroidogenic gene expression upon cAMP signaling pathway stimulation. In osteoblasts, supports transcription activation: phosphorylates RUNX2 that synergizes with SPEN/MINT to enhance FGFR2-mediated activation of the osteocalcin FGF-responsive element (OCFRE).
Applications:
ELISA, IHC
Name of antibody:
HIPK3
Immunogen:
Synthetic peptide of human HIPK3
Full name:
homeodomain interacting protein kinase 3
Synonyms:
PKY; YAK1; DYRK6; FIST3
SwissProt:
Q9H422
ELISA Recommended dilution:
5000-10000
IHC positive control:
Human thyroid cancer;Human esophagus cancer
IHC Recommend dilution:
25-100
技術(shù)規(guī)格

購物車
幫助
021-54845833/15800441009
